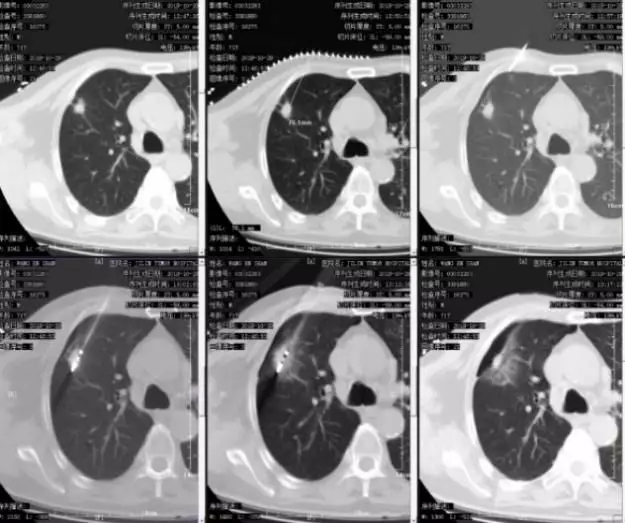
bd6769e8b4f9ccb4021e35498a5c6664.jpg 640.webp (9).jpg

PET-CT在肿瘤疾病诊疗一体化的作用——病例分享
来源:吉林省肿瘤医院 时间:2020-01-07 浏览: 次
患者基本资料:王某,男性,70岁,2017年4月27日体检时发现双肺占位。查体时无阳性体征。PS评分1分。体检时的肺CT:肺窗显示双肺见多发、散在、大小不一的实性结节。纵隔窗显示病灶呈实性结节,见分叶征,边缘毛糙,瘤肺界面清楚。

图一:2017.4.27体检时肺CT
患者于2017年6月到某医院行PET-CT检查,显示除肺内散在病灶外,在患者的右侧鼻咽部发现,咽隐窝消失,鼻咽侧壁黏膜增厚,出现一个高代谢的病灶。当时的PET-CT的诊断是:右肺上叶结节SUVmax5.8,考虑周围型肺癌;双肺结节FDG无代谢,不除外肺转移;右侧鼻咽部高代谢灶SUVmax4.7,延迟后SUVmax6.2不除外恶性;右侧咽旁及颈部小淋巴结,代谢稍增高,待除外转移。

图二:2017.7.6PET-CT检查结果
患者在PET-CT检查后,行鼻咽镜检查,病理结果:(右侧鼻咽部)低分化侵润性鳞状细胞癌。
2017年7月患者于另一家医院进行系统住院治疗。住院后鼻咽部CT显示右侧鼻咽部咽隐窝消失,侧壁黏膜增厚,动脉期轻度强化,延迟区显著强化,病变周围脂肪间隙完整,骨组织未见破坏。临床诊断:鼻咽低分化鳞癌;右肺上叶周围型肺癌可能性大;双肺多发转移可能性大。临床治疗方案:多西他赛联合顺铂的全身化疗。经过4个周期化疗后影像评估发现鼻咽部肿瘤略缩小,无显著变化;而肺内病变化疗前后几乎没有变化。考虑到化疗效果不明显,临床对鼻咽部肿瘤进行放射治疗。计划剂量70Gy,分35次照射。

图三:2017.7化疗前(鼻咽部肿物)

图四:2017.11化疗评估(鼻咽部肿物)略有缩小
当时放疗医师勾画靶区时,参考了之前的PET-CT结果,将右侧鼻咽部高代谢病灶作为肿瘤靶区,从而有效避免邻近组织的不必要照射。体现了PET-CT协助放疗医师更精确的在细胞代谢水平上进行靶区勾画。患者进行12次放疗后,出现了严重的口腔粘膜反应,被迫停止放疗,并未完成根治剂量的照射。放疗后的影像评估显示:鼻咽部肿物明显减小,只是在粘膜上还有少许存在。之后患者没有再进行系统治疗,仅做了定期复查。直到2019年2月辗转至我院治疗。

图五:PET-CT指导放疗靶区勾画图
入院时肺CT显示:右肺上叶及双肺散在病灶增大,于右肺上叶出现新发病灶,提示肿瘤进展。鼻咽部MR对比,显示病变几乎消失。

图六:入我院后肺部病变评估

图七:入我院后鼻咽部病变评估
该患者经过我院多学科会诊,认为鼻咽癌诊断明确,放疗有效。肺部肿物化疗后没有变化,观察期间病灶增大,肺内病变分可能与鼻咽部肿瘤没有密切关系。应首先明确肺内病变的性质,根据病理确定下一步治疗方案。
2019年2月26日,我院参考了患者之前的PET-CT检查结果,直接选取右肺上叶主病灶的高代谢区,进行CT引导的穿刺活检,有效避开坏死组织。病理结果:腺癌,基因检测显示为全野生型。临床明确诊断:鼻咽癌、右肺腺癌同时存在的多原发癌。
我院结合患者的自身情况,临床选择了针对腺癌有效的培美曲塞联合卡铂的全身化疗方案。
经过多个化疗周期后,对患者的治疗情况进行影像评估,发现肺内病灶明显缩小,临床疗效为PR。在这种情况下,临床医生采用PET-CT来评估病灶活性。发现右肺上叶结节SUVmax=2.77,FDG代谢降低,但病灶仍有部分活性,肿瘤细胞尚未完全杀死;右肺上叶新增病灶无活性;右肺下叶结节无活性。

图八:2019.10.21PET-CT检查
关于双肺多发病灶的后续治疗,根据患者的自身状况,首先排除手术。对于是否进行放射治疗:如果对有活性的主病灶进行放疗,剂量少,会导致其他病灶增长的可能;如果全部放疗,剂量过大,将导致严重的放射性肺炎,患者很难耐受。最后经过多学科会诊对肺部高代谢病灶进行消融治疗。
图九:2019.10.29CT引导下进行微波消融治疗
1周后CT复查发现,PET-CT显示有活性的病灶周围,出现1-1.5cm的完整消融环,提示达到了肿瘤活性完全消融的目的。患者目前已出院,病情仍在随访中。

图十:2019.11.4复查CT:病灶周围出现1-1.5cm的消融环。
回顾这个病例:PET-CT在肿瘤疾病诊疗的关键节点发挥重要作用
一、2017年4月-7月在该患者体检发现肺部病变到确诊鼻咽癌,PET-CT全身检查对肿瘤早期发现、诊断、良恶性鉴别起到关键的作用;
二、2017年7月-2019月2月在该患者住院治疗期间,PET-CT全身检查在对鼻咽部肿瘤放疗的靶区勾画、肺部肿物穿刺活检的精准定位起到了重要作用;
三、2019年10月-12月在该患者肺部病变的化疗效果评估和指导局部治疗方面,PET-CT全身起到了指导个体化治疗方案制定的重要作用。

PET-CT在肿瘤诊疗一体化中发挥着重要的临床价值。它在肿瘤早期发现、良恶性鉴别、精确肿瘤分期、.靶区功能、疗效评估、治疗后随访、疗效预测、指导个体化治疗方案制定均发挥着重要的作用。吉林省肿瘤医院PET-CT核医学科,致力于打造充满人文关怀的智慧型、研究型的现代化核医学科,为广大肿瘤患者提供一站式服务。希望越来越多的患者能够从中受益。
PET-CT核医学科 供稿